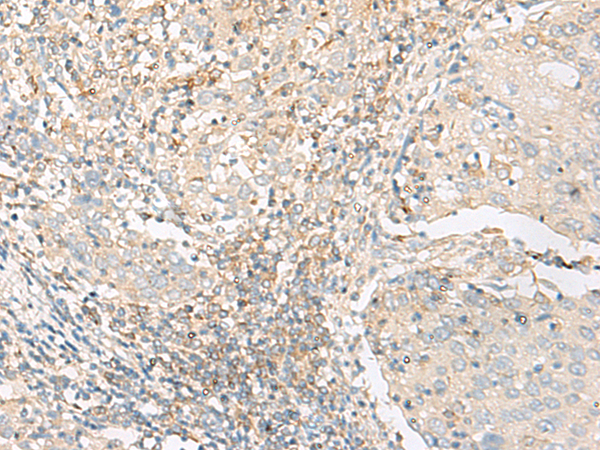

|
Background: |
GLIS1 is a GLI (MIM 165220)-related Kruppel-like zinc finger protein that functions as an activator and repressor of transcription (Kim et al., 2002 [PubMed 12042312]). Binds to the consensus sequence 5'-GACCACCCAC-3' (By similarity). |
|
Applications: |
ELISA, IHC |
|
Name of antibody: |
GLIS1 |
|
Immunogen: |
Synthetic peptide of human GLIS1 |
|
Full name: |
GLIS family zinc finger 1 |
|
SwissProt: |
Q8NBF1 |
|
ELISA Recommended dilution: |
5000-10000 |
|
IHC positive control: |
Human colorectal cancer and Human cervical cancer |
|
IHC Recommend dilution: |
50-300 |
購物車
幫助
021-54845833/15800441009
